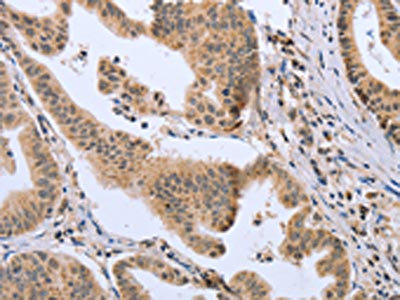

DLD Antibody
-
中文名稱:DLD兔多克隆抗體
-
貨號(hào):CSB-PA783949
-
規(guī)格:¥1100
-
圖片:
-
The image on the left is immunohistochemistry of paraffin-embedded Human gastic cancer tissue using CSB-PA783949(DLD Antibody) at dilution 1/20, on the right is treated with fusion protein. (Original magnification: ×200)
-
The image on the left is immunohistochemistry of paraffin-embedded Human prostate cancer tissue using CSB-PA783949(DLD Antibody) at dilution 1/20, on the right is treated with fusion protein. (Original magnification: ×200)
-
-
其他:
產(chǎn)品詳情
-
Uniprot No.:
-
基因名:DLD
-
別名:Dehydrogenase complex; E3 component antibody; Diaphorase antibody; Dihydrolipoamide dehydrogenase antibody; Dihydrolipoyl dehydrogenase antibody; Dihydrolipoyl dehydrogenase mitochondrial antibody; dld antibody; DLDD antibody; DLDH antibody; DLDH_HUMAN antibody; E3 antibody; E3 branched chain aplha-keto acid antibody; E3 component of pyruvate dehydrogenase antibody; E3 component of pyruvate dehydrogenase complex 2 oxo glutarate complex branched chain keto acid dehydrogenase complex antibody; GCSL antibody; Glycine cleavage system L protein antibody; Glycine cleavage system protein L antibody; LAD antibody; lipoamide dehydrogenase antibody; Lipoamide reductase antibody; Lipoyl dehydrogenase antibody; mitochondrial antibody; OTTHUMP00000206744 antibody; OTTHUMP00000206746 antibody; OTTHUMP00000206748 antibody; OTTHUMP00000206749 antibody; PHE 3 antibody; PHE3 antibody; Pyruvate dehydrogenase component E3 antibody
-
宿主:Rabbit
-
反應(yīng)種屬:Human,Mouse,Rat
-
免疫原:Fusion protein of Human DLD
-
免疫原種屬:Homo sapiens (Human)
-
標(biāo)記方式:Non-conjugated
-
抗體亞型:IgG
-
純化方式:Antigen affinity purification
-
濃度:It differs from different batches. Please contact us to confirm it.
-
保存緩沖液:-20°C, pH7.4 PBS, 0.05% NaN3, 40% Glycerol
-
產(chǎn)品提供形式:Liquid
-
應(yīng)用范圍:ELISA,IHC
-
推薦稀釋比:
Application Recommended Dilution ELISA 1:2000-1:5000 IHC 1:50-1:200 -
Protocols:
-
儲(chǔ)存條件:Upon receipt, store at -20°C or -80°C. Avoid repeated freeze.
-
貨期:Basically, we can dispatch the products out in 1-3 working days after receiving your orders. Delivery time maybe differs from different purchasing way or location, please kindly consult your local distributors for specific delivery time.
-
用途:For Research Use Only. Not for use in diagnostic or therapeutic procedures.
相關(guān)產(chǎn)品
靶點(diǎn)詳情
-
功能:Lipoamide dehydrogenase is a component of the glycine cleavage system as well as an E3 component of three alpha-ketoacid dehydrogenase complexes (pyruvate-, alpha-ketoglutarate-, and branched-chain amino acid-dehydrogenase complex). The 2-oxoglutarate dehydrogenase complex is mainly active in the mitochondrion. A fraction of the 2-oxoglutarate dehydrogenase complex also localizes in the nucleus and is required for lysine succinylation of histones: associates with KAT2A on chromatin and provides succinyl-CoA to histone succinyltransferase KAT2A. In monomeric form may have additional moonlighting function as serine protease. Involved in the hyperactivation of spermatazoa during capacitation and in the spermatazoal acrosome reaction.
-
基因功能參考文獻(xiàn):
- Molecular characterization of dihydrolipoamide dehydrogenase binding sites to titanium dioxide has been reported. PMID: 28247484
- study found that individuals infected with HBV withwith basal core promoter (BCP) double mutations (A1762T, G1764A)have lower concentrations of serum DLD than those with the wild-type BCP PMID: 27303803
- Mitochondrial dihydrolipoamide dehydrogenase is upregulated in response to the brain intermittent hypoxic preconditioning. PMID: 26078703
- IgA autoantibody against DLD could be a novel diagnostic marker for endometrial cancer. PMID: 25202086
- Case Report: novel mutation in the DLD interface giving rise to DLD deficiency. PMID: 20652410
- Human, mouse, and pig Dld has moonlighting function as a protease in addition to its canonical function as a a dehydrogenase. PMID: 17404228
- This molecular dynamics study proposes the structural changes that may lead to the modulation in reactive oxygen species generation by pathogenic mutants of human dihydrolipoamide dehydrogenase. PMID: 24012808
- ATP consumption is demonstrated in respiration-impaired isolated and in situ neuronal somal mitochondria from transgenic mice that exhibit a 20-48% decrease in alpha-ketoglutarate dehydrogenase activity. PMID: 23475850
- the cryptic activities of DLD promote oxidative damage to neighboring molecules and thus contribute to the clinical severity of DLD mutations PMID: 21930696
- Structural and thermodynamic basis for weak interactions between dihydrolipoamide dehydrogenase and subunit-binding domain of the branched-chain alpha-ketoacid dehydrogenase complex. PMID: 21543315
- the E3 binding protein component of the pyruvate dehydrogenase complex appear to be a rare cause of pyruvate dehydrogenase deficiency PMID: 11935326
- Activity of human dihydrolipoamide dehydrogenase is reduced by mutation at threonine-44 of FAD-binding region to valine. PMID: 12297006
- A c.1444A>G substitution in E3 exon 13, predictive of a p.R482G (or R447G in the processed gene product) substitution in a highly conserved domain of the protein was found. PMID: 15712224
- Asparagine-473 residue is important for the catalytic function of dihydrolipoamide dehydrogenase. PMID: 15826505
- the disease-causing mutations of E3 occur at three locations in the human enzyme: the dimer interface, the active site, and the FAD and NAD(+)-binding sites PMID: 15946682
- specificity of pairing for human E3BP with E3 from its subcomplex structure to be most likely due to conformational rigidity of the binding fragment of the E3-binding domain of E3BP and its exquisite amino acid match with the E3 target interface PMID: 16263718
- dihydrolipoamide dehydrogenase PMID: 16442803
- The conservation of the Ile-51 residue with Ala using site-directed mutagenesis in human Dihydrolipoamide dehydrogenase(E3) was very important to the efficient catalytic function of the enzyme. PMID: 16584639
- These results suggest that N286 and D320 play a role in the catalytic function of the E3. PMID: 17171578
- Certain DLD mutations can simultaneously induce the loss of a primary metabolic activity and the gain of a moonlighting proteolytic activity thus contributing to the metabolic derangement associated with DLD deficiency. PMID: 17404228
- kinetic studies suggest that T148 is not important to E3 catalytic function and R281 plays a role in the catalytic function of E3 PMID: 17960497
- This protein has been found differentially expressed in the Wernicke's Area from patients with schizophrenia. PMID: 19405953
顯示更多
收起更多
-
相關(guān)疾病:Dihydrolipoamide dehydrogenase deficiency (DLDD)
-
亞細(xì)胞定位:Mitochondrion matrix. Nucleus. Cell projection, cilium, flagellum. Cytoplasmic vesicle, secretory vesicle, acrosome.
-
蛋白家族:Class-I pyridine nucleotide-disulfide oxidoreductase family
-
數(shù)據(jù)庫(kù)鏈接:
Most popular with customers
-
-
Phospho-YAP1 (S127) Recombinant Monoclonal Antibody
Applications: ELISA, WB, IHC
Species Reactivity: Human
-
-
-
-
-
-